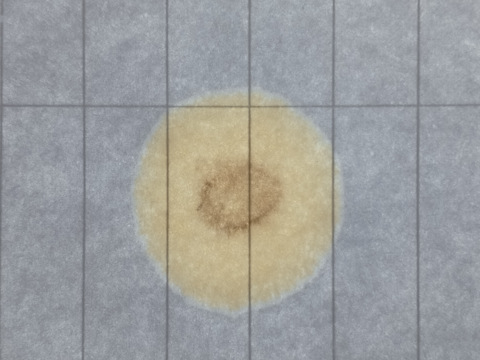

Lada Приора хэтчбек
Lada Приора хэтчбек — наблюдение на DRIVE2



Привет всем! Одна из последних записей была про установку ресивера maxtuning.
После этого, крутил шестеренки, находил + — рабочее положения для данного ресивера.
В целом получилась такая картина, 3…

Возможно глюк какой-то был, так не должно быть по идее. У меня разница 5-6% и то в правильном положении

Какой хх?

Да обычный, стандартный





+2
фотографии
Всем привет! Немного похоливарим и подкину дровишек с маслом в огонь подгорающим.
Вобщем канули в лета байки о присадках, так как изначально они шли от лукавого, точнее от производителей масел, котор…
Машины в продаже

Рубцовск
Лада Приора, 2008
240 000 ₽

Тюмень
Лада Приора, 2011
325 000 ₽

Селижарово
Лада Приора, 2009
230 000 ₽

Светлоград
Лада Приора, 2013
530 000 ₽

Оренбург
Лада Приора, 2011
280 000 ₽

Смоленск
Лада Приора, 2012
430 000 ₽
Реклама





+1
фотография
Так получилось, что этой зимой редко выезжаю на Приоре.
Акк снял. Благо поставить недолго, зарядил предварительно. В январские праздники после долгого простоя в несколько месяцев завелась, словно вче…
Здравствуйте, сегодня решил запустить двигатель после 3 дней простоя, морозы были до 27 до этого, сегодня минус 22. С сигналки авто снял, сел, включил габариты (прогреваю акб), выжимаю сцепление, про…
Вопрос по поводу трапеции дворников стал замечать что при вкл дворников поводки начали останавливаться чуть выше своего штатного места, может кто подскажет в чем причина куда искать куда смотреть, мо…